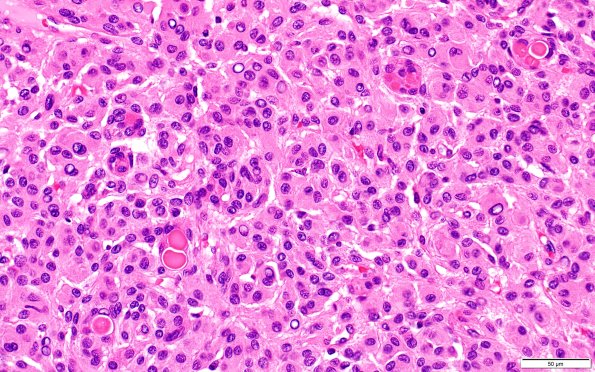
17B1 Meningioma, lipidized (Case 17) 40X 5

Table of Contents
Washington University Experience | NEOPLASMS (MENINGIOMA) | Secretory | 17B1 Meningioma, lipidized (Case 17) 40X 5
17B1,2 H&E-stained sections show a dural-based meningioma, arranged largely in a whorled pattern with numerous mini-whorls. Numerous secretory ("pseudopsammoma") bodies are seen in this routine H&E (17B1) and stain with polyclonal CEA (17B2) stains. The tumor cells have a moderate amount of cytoplasm, indistinct cytoplasmic borders, and predominantly round to oval nuclei with frequent nuclear grooves or clearing and rare intranuclear cytoplasmic pseudoinclusions. Atypical features (necrosis, hypercellularity, sheeting, prominent nucleoli, and/or small cell change) are not identified. The tumor demonstrates dural invasion, including through its entire thickness focally. Mitoses are difficult to find. (H&E)